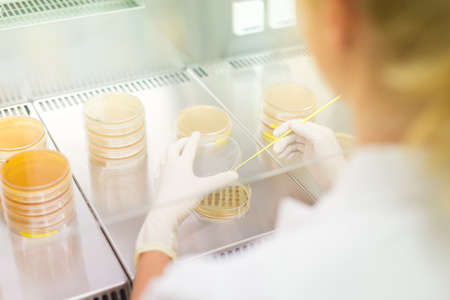
Female scientist researching in laboratory, pipetting cell culture samples on LB agar medium in laminar flow. Life science professional grafting bacteria in the petri dishes.の写真素材

写真素材 - Female scientist researching in laboratory, pipetting cell culture samples on LB agar medium in laminar flow. Life science professional grafting bacteria in the petri dishes.
作品情報
Female scientist researching in laboratory, pipetting cell culture samples on LB agar medium in laminar flow. Life science professional grafting bacteria in the petri dishes.
- ID:41103153
- 作品種別:写真
- 作者名:Matej Kastelic
キーワード
- agar
- analysis
- analyzing
- bacteria
- biology
- biotechnology
- clinic
- coat
- degasser
- develop
- discover
- doctor
- drug
- ebola
- equipment
- experiment
- female
- flask
- glassware
- grow
- health care
- hospital
- investigation
- lab
- laminar
- laminaria
- medical
- medicine
- medium
- micro
- petri dish
- pharma
- pharmacy
- pipette
- research
- researcher
- researching
- sample
- science
- scientific
- scientist
- specialist
- study
- technician
- technology
- test
- virus
- woman
- workspace
- laboratory
類似作品
Young examining...
Botanist resear...
Professional fe...
Young Asian wom...
Scientist afric...
Women in the ch...
Young confident...
Scientist or me...
Scientist in la...
shot of a young...
Young examining...
Young scientist...
Female scientis...
The scientist w...
Women in the ch...
Researcher wear...
Asian researche...
Young female sc...
Closeup of scie...
Woman scientist...
Beautiful young...
Serious female ...
Young woman doi...
Medical Science...
Focused Female ...
African america...
Concentrated vi...
Portrait of sci...
African america...
Young scientist...
Scientist or me...
Female Medical ...
Portrait of bla...
woman scientist...
Female scientis...
A doctor or sci...
Research is not...
Focused female ...
African-america...
Female scientis...
Young medical s...
Concept Coronav...
Female scientis...
Chemical labora...
Woman hairdress...
Close up smart ...
A focused scien...
Microscope, sci...
Research is onl...